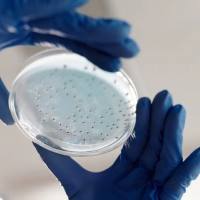
ITS 测序

万千商家帮你免费找货
0 人在求购买到急需产品
- 详细信息
- 技术资料
(一)技术简介:
生化检测(Biochemical detection)是指用生物或化学的方法来对样本进行检测。主要用于测定酶类、糖类、脂类、蛋白和非蛋白氮类、无机元素类等生物化学指标、机体功能指标的诊断方法。
生化检测主要是针对血常规、尿常规、肝功能、肾功能、胰腺、糖尿等疾病的检测。生化检测是最早实现自动化的检测手段,也是目前最常用的体外检测方法之一。
(二)根据检测仪器分类:
常用的生化检测方法根据检测仪器可以分为三种:分光光度法,荧光法,化学发光法。
分光光度法:通过测定被测物质在特定波长处或一定波长范围内光的吸收度,对该物质进行定性和定量的分析方法。它具有灵敏度高、操作简便、快速等优点,是生物化学实验中最常用的实验方法。
荧光法:利用某些物质被紫外光照射后处于激发态,激发态分子经历一个碰撞及发射的去激发过程所发生的能反映出该物质特性的荧光,可以进行定性或定量分析的方法。荧光法的最大特点是:分析灵敏度高、选择性强和使用简便。
化学发光法:由于化学反应(通常是氧化)产生电子能级处于激发态的物质,后者通过跃迁释放能量产生光子,从而导致的发光现象。化学发光法不需要任何光源,灵敏度较高,此外线性范围宽和仪器简单也是其特点之一。基于这些特点,化学发光法在环境化学、临床检验、药物分析等领域得到十分广泛的应用和研究。
(三)根据检测指标分类:
常见的生化检测可分为两类:酶活检测,底物或产物检测。

常用的酶活检测方法是在酶和底物作用一段时间后停止酶反应,加入各种化学试剂与产物或基质反应呈色,用分光光度计测出OD值,同时将被测物质作标准管或标准曲线,比较后计算出在此段时间内产物生成量或底物消耗量,从而求得反应速率。
例如:碱性磷酸酶检测,pN P P是一种常用的磷酸酶显色底物,在碱性条件下,可在碱性磷酸酶作用下生成黄色产物, 通过检测400-415nm处吸光度可以计算出碱性磷酸酶活性。

底物检测一般是在酶和底物作用一段时间后停止酶反应,加入各种化学试剂与产物或基质反应呈色,用分光光度计测出OD值,同时将被测物质作标准管或标准曲线,比较后计算出在此段时间内产物生成量,从而计算出底物的浓度。
例如:过氧化氢检测,过氧化氢氧化二价铁离子产生三价铁离子,然后和 xylenol orange在特定的溶液中形成紫色的产物,通过检测560nm处吸光度可以计算出过氧化氢含量。
产物检测一般是加入各种化学试剂或荧光试剂与产物反应,用分光光度计或荧光光度计测出OD值或荧光值,由此可计算出产物的浓度。
例如:活性氧检测,DCFH-DA本身没有荧光,可以自由穿过细胞膜,进入细胞内后,可以被细胞内的酯酶水解生成DCFH。细胞内的活性氧可以氧化无荧光的DCFH 生成有荧光的DCF。检测DCF的荧光就可以知道细胞内活性氧的水平。
(四)技术优势:
1、技术服务人员拥有丰富的操作经验和精湛的技术,保证高效、精准地完成检测;
2、提供丰富的生化检测试剂盒,可以涵盖大多数生化指标;
3、以最 优惠的价格为客户提供最全面的服务,帮助客户有效节约科研经费;
4、拥有全套检测设备和专业实验平台,在最短的时间内为客户提供服务。
(五)检测流程:
确认样本和试剂盒信息→正式实验→结果整理→数据分析→交付结果报告。
(六)样品要求:
1、在收集标本前必须清楚要检测的成份是否稳定。我们提倡新鲜标本尽早检测,收集后当天就进行检测的标本,应及时储存在4℃备用,如有特殊原因需要周期收集标本,请造模取材后,将标本及时分装后放在-20℃或-70℃下保存。
2、液体类标本:标本必须不含沉淀。包括血清、血浆、尿液、胸腹水、脑脊液、细胞培养上清、组织匀浆等。
3、血清:血液在室温自然凝固10-20分钟后,离心20分钟左右(2000-3000转/分),收集上清。如有沉淀,应再次离心。
4、血浆:应根据试剂盒的要求选择EDTA、柠檬酸钠或肝素作为抗凝剂,加入10%(v/v)抗凝剂(0.1M柠檬酸钠或1%heparin 或2.0%EDTA.Na2)混合10-20分钟后,离心20分钟左右(2000-3000转/分),收集上清。如有沉淀,应再次离心。
5、细胞培养上清:检测分泌性物质时,用无菌管收集。离心20分钟左右(2000-3000转/分),收集上清。检测细胞内物质时,用PBS(PH7.0-7.4)稀释细胞悬液,使细胞浓度达到100万/ml左右。通过反复冻融,使细胞破坏并释放出细胞内物质。离心20分钟左右(2000-3000转/分),收集上清。保存过程中如有沉淀,应再次离心。
6、组织标本:切割标本后,称取重量。加入一定量的PBS,缓冲液中可加入1μg/L蛋白酶抑制剂或50U/ml的Aprotinin(抑肽酶)。用手工或匀浆器将标本匀浆充分。离心20分钟左右(2000-3000转/分),收集上清置于-20度或-70度保存,如有必要,可以将样品浓缩干燥。分装后一份待检测,其余冷冻备用。
7、运输要求:干冰或冰袋寄送,样本应避免各类污染和反复冻融。
(七)实验交付内容:
1、实验报告;
2、数据分析结果;
3、原始数据。
风险提示:丁香通仅作为第三方平台,为商家信息发布提供平台空间。用户咨询产品时请注意保护个人信息及财产安全,合理判断,谨慎选购商品,商家和用户对交易行为负责。对于医疗器械类产品,请先查证核实企业经营资质和医疗器械产品注册证情况。
技术资料暂无技术资料 索取技术资料